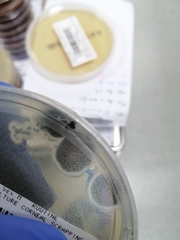
Aspergillus
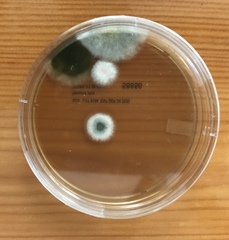
Aspergillus

Aspergillus: taxon details and analytics
- Domain
- Kingdom
- Fungi
- Phylum
- Ascomycota
- Class
- Eurotiomycetes
- Order
- Eurotiales
- Family
- Aspergillaceae
- Genus
- Aspergillus
- Species
- Scientific Name
- Aspergillus
Summary description from Wikipedia:
Aspergillus
Aspergillus () is a genus consisting of several hundred mold species found in various climates worldwide.
Aspergillus was first catalogued in 1729 by the Italian priest and biologist Pier Antonio Micheli. Viewing the fungi under a microscope, Micheli was reminded of the shape of an aspergillum (holy water sprinkler), from Latin spargere (to sprinkle), and named the genus accordingly. Aspergillum is an asexual spore-forming structure common to all Aspergillus species; around one-third of species are also known to have a sexual stage. While some species of Aspergillus are known to cause fungal infections, others are of commercial importance.
...Aspergillus in languages:
- English
- Aspergillus subg. Aspergillus
Images from inaturalist.org observations:
We recommend you sign up for this excellent, free service.